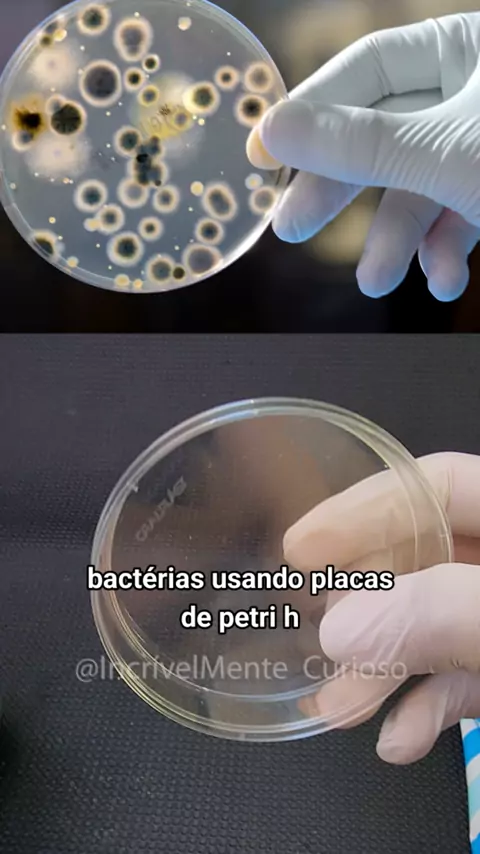

IncrivelmenteCuriosoYT

378
Posts

All playlists · Total 22

6
Seu cachorro tbm tem isso? #cachorro #microscopio #viral #fy #dog

2
TESTANDO BRINQUEDOS impressos em 3D #2025internationalshortvideocompetition #impressao3d #brinquedos

2
Imprimindo abacatudo em 3D #2025internationalshortvideocompetition #abacatudo #impressao3d #JogoDeChatComPremios

2
Imprimi algo que NÃO deveria existir… 😳 (Impressão 3D) #FelizPascoa #2025internationalshortvideocompetition

2
Imprimindo coisas para Crianças na inpressora 3D #criançafeliz #diadonordestino #SequênciaFeiticeiraNoKwai

2
imprindo brinquedos incríveis na impressora 3D #maisviews #lindaementirosa #impressao3d

2
imprimindo coisas para casa na impressora 3d #Cantakwai #NãoSeiQueAconteceu #viraliza

3
IMPRIMINDO COISAS PARA CASA NA IMPRESSORA 3D #mejalo #viraliza #maisviews

2
imprimindo coisas na impressora 3d #ProvaDoAnjoKwaiLite #daumavoltinha #JogadinhaDaMelissa

5
A planta carnivora é muito forte! #plantacarnivora #plantas #escorpião #desafio #incrivel

2
imprimindo coisas Incríveis na impressora 3D #DesafioDaPelúcia #ResenhaDoArrochaNoKwai #TrendDoWillSmith

3
4RMA 3D VS Arma de brinquedo! qual é a melhor? #entaoenatal #maisviews #3D

2
eternizei um coração na resina #coracao #resina #viraliza

2
Alimentei minha Planta Carnívora com Escorpiões

2
Alimentei a Planta Carnívora com Escorpião
2
O que tem mais Bactérias? Gato, Celular ou Dinheiro ? #topz

2
coloquei as unhas no microscópio #topz

2
Alimentei a planta Carnívora com carne

3
coloquei a tartaruga na resina #kwaicriador #videoslongos #resina #viral

2
Planta carnívora comendo planta carnívora #kwaicriador #fy #videoslongos #KwaiFamilia #plantacarnivora





















